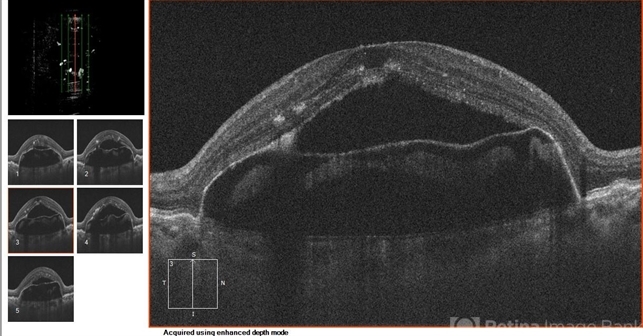
file

-
 By Eitae Kim, MD
By Eitae Kim, MD
Kims retina clinic - Uploaded on Aug 1, 2017.
- Last modified by Caroline Bozell on Aug 1, 2017.
- Rating
- Appears in
- Miscellaneous
- Condition/keywords
- optical coherence tomography (OCT)
- Photographer
- Eitae Kim, BOIM retinal center, Pureun eye hospital
- Imaging device
-
Optical coherence tomography system
Cirrus, Zeiss - Description
- OCT of 78-year-old male with advanced AMD after 6 injections of bevacizumab.

Initializing download.
Initializing download.










